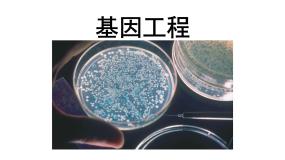
人教版 (新课标)必修2《遗传与进化》第2节 基因工程及其应用图片课件ppt

人教版 (新课标)必修2《遗传与进化》基因工程及其应用复习ppt课件
这是一份人教版 (新课标)必修2《遗传与进化》基因工程及其应用复习ppt课件,共22页。PPT课件主要包含了基因工程的原理,DNA重组技术,DNA分子,限制性核酸内切酶,核苷酸,DNA连接酶,脱氧核糖,基本操作步骤,抗逆性,转基因抗虫棉等内容,欢迎下载使用。

人教版 (新课标)必修2《遗传与进化》基因工程及其应用示范课ppt课件
这是一份人教版 (新课标)必修2《遗传与进化》基因工程及其应用示范课ppt课件,共33页。PPT课件主要包含了基因工程的原理,基因工程的应用,转基因的安全性,微生物,已发现的有200多种,这个特点说明了,酶具有专一性,指“DNA连接酶”,目的基因的提取等内容,欢迎下载使用。

人教版 (新课标)必修2《遗传与进化》基因工程及其应用示范课课件ppt
这是一份人教版 (新课标)必修2《遗传与进化》基因工程及其应用示范课课件ppt,共27页。PPT课件主要包含了一基因工程定义,基因工程的工具,基因的针线,基因的运载体,基因工程的应用等内容,欢迎下载使用。

人教版 (新课标)必修2《遗传与进化》基因工程及其应用课前预习课件ppt
这是一份人教版 (新课标)必修2《遗传与进化》基因工程及其应用课前预习课件ppt,共28页。PPT课件主要包含了世界上首束蓝玫瑰,转基因黄金大米,1基因工程简介,奇思妙想,阅读资料,设计思路,简要步骤,自主建模,表达交流,如何让奶牛产生人奶等内容,欢迎下载使用。

高中生物人教版 (新课标)必修2《遗传与进化》基因工程及其应用示范课课件ppt
这是一份高中生物人教版 (新课标)必修2《遗传与进化》基因工程及其应用示范课课件ppt,共19页。PPT课件主要包含了操作水平,基因重组,DNA分子水平等内容,欢迎下载使用。

高中生物人教版 (新课标)必修2《遗传与进化》杂交育种与诱变育种备课课件ppt
这是一份高中生物人教版 (新课标)必修2《遗传与进化》杂交育种与诱变育种备课课件ppt,共21页。PPT课件主要包含了杂交育种,诱变育种等内容,欢迎下载使用。

这是一份必修2《遗传与进化》杂交育种与诱变育种复习课件ppt,共25页。PPT课件主要包含了杂交育种,优良性状,选择和培育,基因重组,诱变育种,突变率等内容,欢迎下载使用。

高中生物人教版 (新课标)必修2《遗传与进化》杂交育种与诱变育种评课课件ppt
这是一份高中生物人教版 (新课标)必修2《遗传与进化》杂交育种与诱变育种评课课件ppt,共19页。PPT课件主要包含了选择育种,汰劣留良,袁隆平的表情,杂交育种等内容,欢迎下载使用。

人教版 (新课标)必修2《遗传与进化》杂交育种与诱变育种课前预习ppt课件
这是一份人教版 (新课标)必修2《遗传与进化》杂交育种与诱变育种课前预习ppt课件,共15页。PPT课件主要包含了第六章育种,基因重组,任务2,任务3,实践应用,多倍体育种等内容,欢迎下载使用。

人教版 (新课标)必修2《遗传与进化》第1节 杂交育种与诱变育种背景图课件ppt
这是一份人教版 (新课标)必修2《遗传与进化》第1节 杂交育种与诱变育种背景图课件ppt,共19页。PPT课件主要包含了粒饱的玉米,优良玉米品种,二杂交育种,培育显性性状的纯合子,连续自交多次,能稳定遗传的,遗传图解与描述,以单显为例,DDTT,ddtt等内容,欢迎下载使用。
人教版 (新课标)必修2《遗传与进化》第2节 基因工程及其应用图片课件ppt
这是一份人教版 (新课标)必修2《遗传与进化》第2节 基因工程及其应用图片课件ppt,共33页。PPT课件主要包含了基因工程,DNA重组技术,DNA分子,获取目的基因,切割磷酸二酯键,黏性末端,平末端,限制性内切酶,作用特点,专一性和特异性等内容,欢迎下载使用。

人教版 (新课标)必修2《遗传与进化》第1节 杂交育种与诱变育种优秀ppt课件
这是一份人教版 (新课标)必修2《遗传与进化》第1节 杂交育种与诱变育种优秀ppt课件,共11页。PPT课件主要包含了受精作用等内容,欢迎下载使用。

人教版 (新课标)必修2《遗传与进化》第1节 杂交育种与诱变育种课文配套课件ppt
这是一份人教版 (新课标)必修2《遗传与进化》第1节 杂交育种与诱变育种课文配套课件ppt,共36页。PPT课件主要包含了杂交育种,优良性状,选择和培育,基因重组,不发生性状分离,杂交育种的类型,诱变育种,基因突变,物理因素,化学因素等内容,欢迎下载使用。

高中生物人教版 (新课标)必修2《遗传与进化》第1节 杂交育种与诱变育种课文课件ppt
这是一份高中生物人教版 (新课标)必修2《遗传与进化》第1节 杂交育种与诱变育种课文课件ppt,共29页。PPT课件主要包含了选择育种,DDTT,ddtt,DdTt,单倍体育种,基因突变,诱变育种,诱变育种太空育种,随堂巩固等内容,欢迎下载使用。
必修2《遗传与进化》生物精品专辑

教习网精选60套人教版 (新课标)生物必修2《遗传与进化》从杂交育种到基因工程课文配套ppt课件,ppt设计精美,配图清晰,包含音视频素材,其中不乏一等奖获奖ppt课件,可用于同步教学,也可用于优质课或公开课等设计参考,欢迎下载使用。
资料篮
在线客服
添加在线客服
获取1对1服务
官方微信
关注“教习网”公众号
打开微信就能找资料
赛课定制
添加在线客服
获取1对1定制服务
职称咨询
添加在线客服
获取1V1专业指导服务
免费福利
